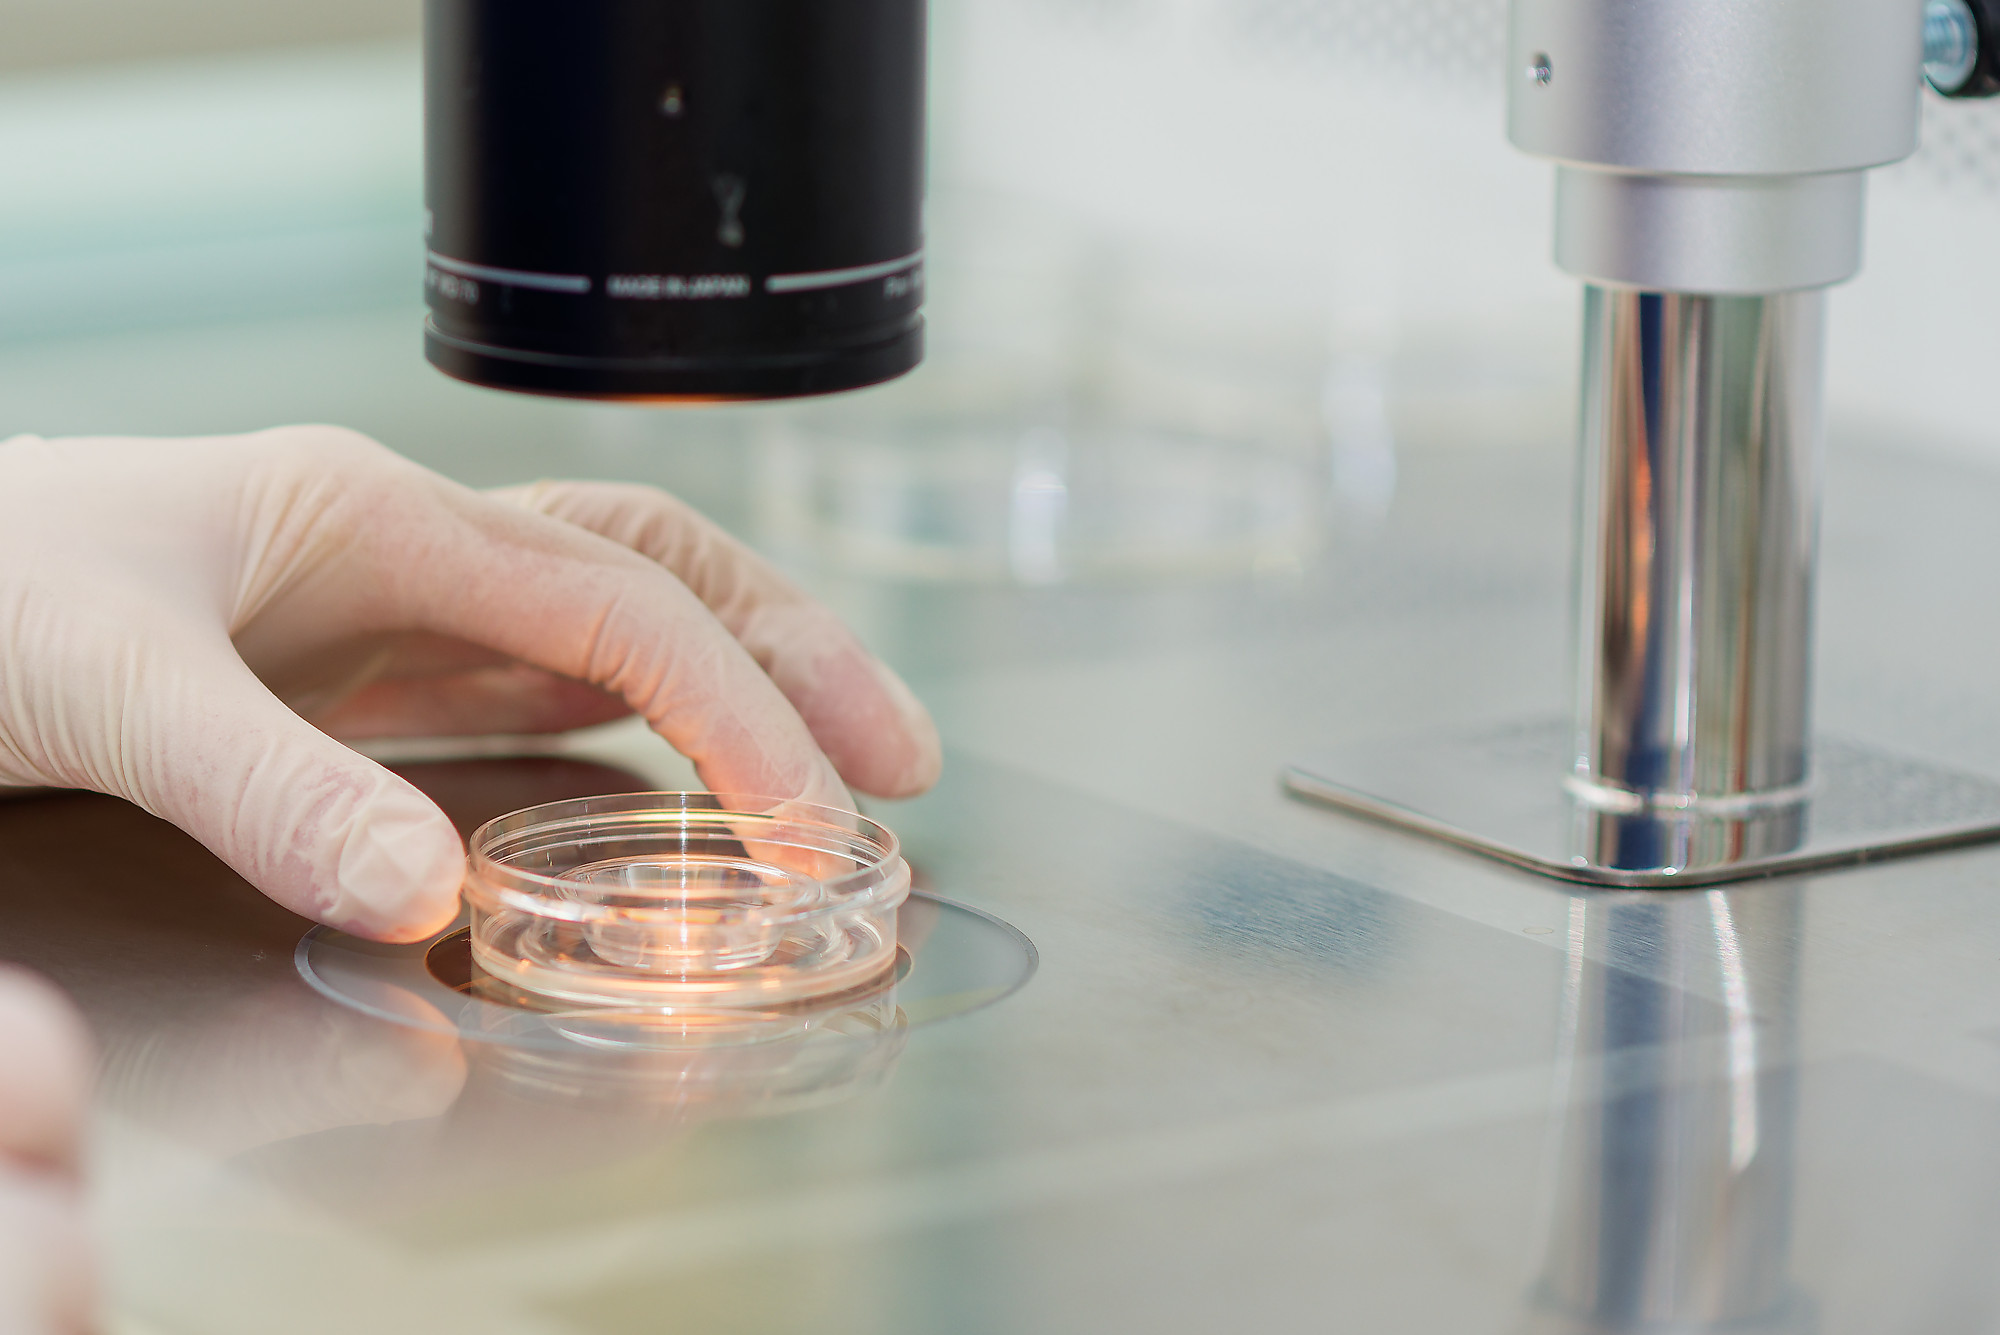

- Kirurgija
- Spodbujanje ovulacije
- Intrauterina inseminacija
- Zunajtelesna oploditev
V določenih primerih, kadar s pregledom in ultrazvočno preiskavo ne najdemo vzroka za neplodnost, za opredelitev vzroka predlagamo kirurški poseg. Posegi, ki jih izvajamo v lastni operacijski dvorani, so večinoma endoskopski (laparoskopija, histeroskopija). Ti posegi so minimalno invazivni in omogočajo hitro okrevanje in vrnitev k vsakodnevnim dejavnostim. V drugih okoliščinah pa je kirurško zdravljenje potrebno za zdravljenje stanj, ki jih odkrijemo pri pregledu in vemo, da povzročajo neplodnost ali za izboljšanje možnosti za zanositev v postopku zunajtelesne oploditve.
Posegi, ki jih izvajamo:
Ambulantna histeroskopija
Je poseg, kjer z izredno tankim inštrumentom, ki ima kamero in nastavek za delovne instrumente brez anestezije pogledamo v notranjost (votlino) maternice. S tem posegom lahko odstranimo manjše polipe in odvzamemo vzorček sluznice maternice za histološko preiskavo. Poseg je ambulantni, kar pomeni, da ste takoj po posegu odpuščeni domov. Za poseg ni potrebno, da ste tešči.
Histeroskopija
Tudi pri tem posegu pogledamo maternično votlino s kamero. Ker je inštrument debelejši kot tisti za ambulantno histeroskopijo, ga izvajamo v kratkotrajni splošni anesteziji. S tem posegom odstranjujemo pregrade maternice, večje polipe, miome, zarastline v maternici. Ker se izvaja v splošni anesteziji, je potrebno, da ste pred posegom tešči. Domov ste odpuščeni nekaj ur po posegu (link za naročanje na poseg).
Laparoskopija
Je poseg pri katerem s kamero, ki jo vstavimo skozi popek, pregledamo organe trebušne votline in male medenice. Tudi laparoskopija se izvaja v splošni anesteziji. Poseg je lahko le diagnostični (iščemo vzroke neplodnosti) ali terapevtski (odstranimo bolezenske spremembe). Izvajamo jo za diagnosticiranje in razrešitev zarastlin v trebušni votlini, okoli jajcevodov in jajčnikov, za diagnosticiranje in zdravljenje endometrioze, za odstranjevanje miomov in cist jajčnikov. Trajanje posega je odvisno od vrste posega. Po posegu prenočite v bolnišnici. Trajanje hospitalizacije je odvisno od vrste izvedenega posega (link za naročanje na poseg). Za doseganje želenega rezultata po posegu in ohranitev plodne sposobnosti je ključno, da posege pri neplodnih ženskah in pri ženskah v rodni dobi izvede specialist, ki ima izkušnje s tovrstnimi posegi.
Motnje ovulacije so eden najpogostejših vzrokov ženske neplodnosti. Z zdravili za spodbujanje ovulacije poskušamo doseči ustrezno hormonsko ravnovesje, ki omogoči razvoj jajčnih foliklov in predvidljivo ovulacijo. Spodbujanja ovulacije se večinoma poslužujemo pri ženskah z nerednimi menstruacijskimi ciklusi. Lahko pa ga uporabimo tudi pri parih z nepojasnjeno neplodnostjo. Če z ultrazvočno preiskavo potrdimo rast folikla lahko ocenimo plodno obdobje v menstruacijskem ciklusu. V tem času vam svetujemo redne nezaščitene spolne odnose ali pa izvedemo intrauterino inseminacijo (IUI).
Intrauterina inseminacija (IUI) je postopek oploditve z biomedicinsko pomočjo (OBMP), pri katerem preko tankega katetra vbrizgamo partnerjevo seme neposredno v maternico. Poseg je neboleč, podoben običajnemu ginekološkemu pregledu.
Za koga je postopek primeren?
- Za pare z nepojasnjeno neplodnostjo
- Za pare z blago moško neplodnostjo
- Za pare, kjer je pri ženski prisotna motnja ovulacije (neredni menstruacijski ciklusi)
- Ob drugih vzrokih neplodnosti: neprehoden maternični vrat, erektilna disfunkcija...
Kako poteka postopek IUI?
Postopek se vedno začne s prvim obiskom v Ambulanti za zdravljenje neplodnosti, kjer zdravnik vzame natančno anamnezo in naredi ultrazvok. Nato ženskam odvzamemo kri za hormonske preiskave, moški pa opravi spremiogram. Šele na osnovi teh preiskav se bo zdravnik odločil, ali je IUI primerna metoda OBMP v vašem primeru. Preden izvedemo postopek IUI običajno opravimo še test prehodnosti jajcevodov (HSSG, laparoskopija). Preden izvedemo postopek IUI običajno ženski predpišemo zdravila za spodbujanje ovulacije. Sledijo serijske ultrazvočne preiskave, s katerimi spremljamo rast in velikost vodilnega folikla/foliklov. Ob ustrezni velikosti folikla prejmete injekcijo za zorenje jajčnih celic, ki ji sledi sam postopek IUI. Po postopku prejemate progesteron za podporo lutealni fazi menstruacijskega ciklusa. Režim jemanja vam bo razložil vaš lečeči zdravnik. Po 14 dneh od inseminacije doma opravite test nosečnosti in, če je pozitiven, se naročite na kontrolni ultrazvok za potrditev nosečnosti.
Najučinkovitejša metoda OBMP je zunajtelesna oploditev ženske jajčne celice s semenom partnerja v laboratoriju – t.i. IVF. Vaše jajčne celice običajno pridobimo po predhodnem spodbujanju jajčnikov s hormonskimi injekcijami. Embriologi nato v laboratoriju po predpripravi semena vašega partnerja izvedejo postopek IVF. Po 3. oziroma 5. dneh gojenja opravimo prenos zarodka nazaj v maternico, nadštevilne zarodke visoke kakovosti pa zamrznemo za poznejšo uporabo.
V našem embriološkem laboratoriju izvajamo obe tehniki:
- Klasičen IVF – prepripravljeno seme in jajčne celice inkubiramo v Petrijevki. Oploditev jajčne celice poteka podobno kot v telesu.
- ICSI – embriolog pod veliko povečavo mikroskopa poišče semenčico in jo vbrizga neposredno v jajčno celico. To metodo izvajamo pri težkih oblikah moške neplodnosti ali po predhodnih neuspelih oploditvah jajčnih celic s klasičnim IVF.
Kdaj izvedemo IVF/ICSI?
- Pri neprehodnih ali odsotnih jajcevodih
- Pri moški neplodnosti
- Ko smo izčrpali ostale možnosti zdravljenja neplodnosti ali le-te niso možne

Kako poteka postopek IVF/ICSI?
Postopek se vedno začne s prvim obiskom v Ambulanti za zdravljenje neplodnosti, kjer zdravnik vzame natančno anamnezo in naredi ultrazvok. Nato ženskam odvzamemo kri za hormonske preiskave, moški pa opravi spremiogram. Na osnovi teh preiskav se bo zdravnik specialist, ki vodi vaše zdravljenje, odločil, ali je metoda IVF/ICSI primerna za vas in vam predlagal individualno prilagojen načrt zdravljenja. Za povečanje uspešnosti postopka IVF/ICSI se poslužimo hormonskega spodbujanja jajčnikov. S hormonskim spodbujanjem začasno nadomestimo vaš naravni menstruacijski ciklus z medicinsko nadzorovanim ciklusom. Na ta način povečamo možnost, da v enem menstruacijskem ciklusu pridobimo več kot eno jajčno celico, ki je sposobna oploditve in razvoja v zarodek. Odmerek hormonov vam individualno prilagodimo glede na rezultate predhodnih preiskav. Odziv jajčnikov spremljamo s serijskimi ultrazvočnimi meritvami na osnovi katerih se odločimo, kdaj je pravi čas za aplikacijo zdravila za zorenje jajčnih celic (t.i. »STOP« injekcija). Dva dni po aplikaciji tega zdravila se na oddelku zglasita oba s partnerjem. Partner s seboj prinese sveže seme, lahko pa vzorec semena odda tudi na oddelku. Jajčne celice iz vaših jajčnikov pridobimo z ultrazvočno vodeno punkcijo preko nožnice. Poseg lahko izvedemo bodisi v lokalni analgeziji(lokalni anestetik) ali v analgosedaciji. Analgosedacija je postopek, ki ga izvede eden izmed naših zdravnikov specialistov anesteziologov. Preko intravenskega kanala vam aplicira uspavalo, pomirjevalo in protibolečinsko zdravilo. Jajčne celice in seme vašega partnerja nato predamo v embriološki laboratorij kjer embriolog izvede oploditev jajčnih celic bodisi z metodo IVF bodisi z ICSI. Naslednji dan embriolog preveri oplojenost jajčnih celic in zarodke goji v inkubatorjih, v pogojih, ki so čim bolj podobni pogojem v telesu. Tretji oziroma peti dan po punkciji opravimo prenos zarodka v maternico. Po prenosu svetujemo relativni počitek. To pomeni, da se izogibate težkim telesnim aktivnostim, dvigovanju težkih predmetov, spolnim odnosom, vročim kopelim, savnanju. Nadaljujete z uporabo progesterona skladno z navodili, ki jih prejmete na oddelku. Obdobje čakanja do krvnega testa nosečnosti je eno najtežjih obdobij v postopku IVF. Pomeni stanje nesigurnosti, velikega pričakovanja in strahu pred neuspehom. Svetujemo, da se v tem obdobju poskušate čim bolj sprostiti, izogibate stresu in da počnete stvari, ki vas veselijo.

Prenos zamrznjenih zarodkov
Med postopkom IVF/ICSI se lahko v laboratoriju razvije več kot en zarodek. Nadštevilni visoko kakovostni zarodki se v tem primeru zamrznejo (vitrifikacija). Če vam po prvem prenosu ne uspe zanositi ali če želite pozneje ponovno zanositi, prenesemo enega izmed teh zarodkov. Prenos zamrznjenih zarodkov je za žensko manj obremenjujoč, saj ne potrebuje hormonskih injekcij. Največkrat ga izvedemo v naravnem menstruacijskem ciklusu, redkeje ob uporabi zdravil za indukcijo ovulacije ali za pripravo maternične sluznice. Verjetnost za zanositev po prenosu zamrznjenega zarodka je primerljiva z verjetnostjo po prenosu svežega zarodka. Prenos zamrznjenega zarodka se šteje pod tisti postopek v katerem ste prejemali zdravila za spodbujanje jajčnikov in je bil zarodek shranjen. Preden lahko pričnete z novim postopkom spodbujanja jajčnikov z zdravili morate porabiti vse predhodno zamrznjene zarodke. Zarodki so shranjeni za dobo 5 let. Po 5 letih je možno Državno komisijo za OBMP zaprositi za podaljšanje hranjenja za nadaljnjih 5 let.
